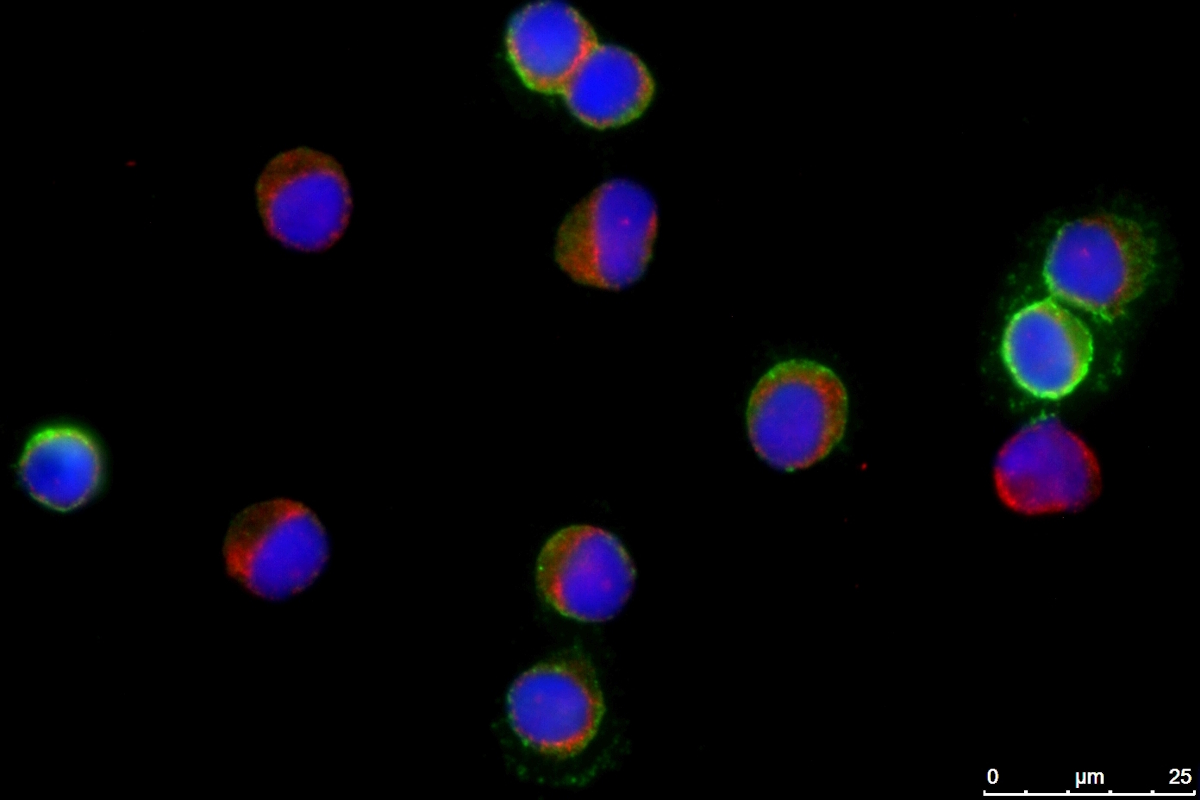

Services
- Custom-built models
- High quality biological and regulatory insight
- Full-service in-house execution

Build your model

We create physiologically accurate models of a wide range of barrier tissues—including lung, gut, bladder, kidney, and more—customized to your specific needs.
Through close collaboration with biobanks worldwide, we can source precise tissue types and donor profiles (from pediatric to adult, including disease-specific samples) to ensure your study objectives align with clinical relevance.





Primary Cells: HLA- and donor-matched available | Pediatric, elderly, pregnant, and disease-specific donors | Clinical background available on request
Immortalized: Robustness | Reproducibility | Standardization | Including our proprietary human alveolar epithelial cell line with strong TER formation
Organoids: Patient-derived, tissue-specific 3D models | Maintain phenotypic fidelity and offer high throughput compatibility

With AlveoliX, you define the level of innovation for your research—from classic cell culture plates to advanced Transwell inserts and state-of-the-art organ-on-chip systems. We offer flexibility across complexity factors—ensuring your model matches your scientific objective:
- Mono-, Co-, or Multi-culture systems
- Air–liquid interface or submerged
- Immune competent cultures
- Static or dynamic conditions






The model needs to be fine-tuned according to your specific molecule or compound and the objectives of your project. Our expertise spans a variety of areas, including:
- Small molecules
- Antibodies, proteins, and bioconjugates
- Nucleic acid-based therapeutics
- Nanomaterials and nanoparticles
- Drug delivery systems
- Excipients and formulation components
In partnership with Alexis and VitroCell, we provide various administration methods such as submerged exposure, nebulization, and dry powder delivery.





Available readouts
The AX12 chip simplifies TEER measurements, enabling easy integration with existing systems. When paired with our TEEROC, it delivers fully automated, robust, and reproducible barrier integrity assessments—saving valuable time.
The platform’s design facilitates straightforward sampling from both apical and basolateral chambers, enabling precise analysis of molecular diffusion and cellular transmigration.
Thanks to its configuration, the AX12 platform allows rapid, efficient supernatant collection, ideal for downstream protein and cytokine quantification using ELISA, multiplex immunoassays, or mass spectrometry.
Fully compatible with advanced omics workflows—including transcriptomics, proteomics, and metabolomics—the AX12 platform enables comprehensive cellular and molecular profiling in barrier tissue models.
TEER evaluates barrier function and cell layer integrity to investigate gut permeability, , lung EDEMA or drug-induced barrier impairment.
Permeability Assay evaluates on one hand passive transport of a molecule across a cell barrier and therefore barrier-tightness, on the other hand active molecule transport across a barrier. This assay can be used to investigate barrier tightness like TEER or to study in vitro ADME for molecule or drug transport, uptake or delivery.
Live cell imaging allows assessment of cell morphology, cytotoxicity or drug uptake throughout the cell experiment.
Immunofluorescent staining is applied to visualize cell morphology and expressed proteins at high magnification, to evaluate for instance cell shape, target detection or changes in pathological markers upon molecule exposure.
Protein and cytokine secretion can be measured by immunoassays or high throughput proteomics across different cellular compartments allowing the observation of changes in protein secretion following exposure to specific molecules. This enables the detection of key disease or clinical markers, as well as profiling of inflammatory responses, supporting pathway analysis, biomarker discovery, and investigations into mechanisms of action.
Gene expression analysis is possible for single cells or cell populations on the chip, e.g. to check for presence of targets, or changes in disease or inflammatory markers following exposure to specific molecules, supporting pathway analysis, biomarker discovery or investigations into mechanisms of action.
In light of the recent FDA Modernization Acts, which emphasize the integration of new approach methodologies (NAMs) and reduce reliance on animal testing and also the ban of animal testing for other sectors like the cosmetic and chemical industry, AlveoliX’s advanced in-vitro models are well-positioned to support regulatory-aligned, human-relevant preclinical strategies.
AlveoliX is one of the first companies who supported regulatory submission for IND applications with organs-on-chip data. We have a strong network of experts and stakeholders in the field. We collaborate closely with regulatory consultants to support your de-risking and preclinical strategy, ensuring that the use of complex in-vitro models aligns with current and emerging regulatory expectations.
Applications

Explore our case studies

Leveraging the deep expertise of our lung specialists, our lung‑on‑Chip models accurately replicate key regions of the lung—including the alveolar barrier and bronchial airways. They are available in different levels of complexity (from mono‑ to triple‑culture systems, including air–liquid interface models and breathing like motion) and can be generated using primary cells or cell lines. These models are well suited for both safety assessment and efficacy testing.


Our gut-on-chip model, based on human primary cells or cell lines, exhibits robust barrier integrity and incorporates key epithelial subtypes to create a physiologically relevant system under peristalsis. This platform offers a reliable solution for evaluating compound and nutrient efficacy, as well as gastrointestinal toxicity in response to oral drugs and biologics.


Renal proximal tubular epithelial cells (RPTECs) are cultured on‑chip to reproduce the structure and functionality of the proximal tubule, creating a simple yet sufficiently complex model capable of evaluating compound‑induced nephrotoxicity and studying excretion processes and dynamics related to ADME.


Our interstitial lung disease model, composed of donor-derived epithelial cells and lung fibroblasts, demonstrates key fibrotic markers, with efficacy testing validated using the FDA-approved drug nintedanib. In addition, our proprietary epithelial cell line, when combined with lung fibroblasts and fibrotic inducer, exhibits characteristic fibrotic hallmarks. Both models provide robust platforms for evaluating anti-fibrotic compound efficacy and assessing safety related to fibrotic risk.


Our Gut-on-Chip models recreate key inflammatory processes underlying Crohn’s disease and ulcerative colitis by integrating human intestinal epithelial co‑cultures with physiologically relevant biomechanical cues. Exposing epithelial cells to controlled pro‑inflammatory cytokine cocktails, the Gut‑on‑Chip platform enables the induction of a ‘leaky‑gut’ phenotype characterized by barrier disruption, altered epithelial differentiation, increased cytokine release, and immune‑modulated responses. The incorporation of rhythmic, peristalsis‑like mechanical stretch enhances model sensitivity to inflammatory triggers and more accurately reflects in vivo intestinal dynamics.


Our COPD models recreate key physiological features of the diseased lung, enabling controlled and reproducible investigation of chronic obstructive pulmonary disease mechanisms. Using human alveolar and airway cell types cultured under air–liquid interface and breathing‑like mechanical stretch, these Lung‑on‑Chip systems allow the study of inflammatory responses, barrier dysfunction, oxidative stress, and tissue remodeling characteristic of COPD.


Our infection models allow the study of both viral (e.g. SARS-CoV-s, influenza) and bacterial pathogens (e.g. S. pneumoniae, E. coli) under physiologically relevant conditions. These models support a wide range of functional readouts reflecting native tissue responses—such as barrier integrity, cytokine release, pathogen replication dynamics, and host–pathogen interactions. Moreover, the models can be operated within BSL‑3 facilities, enabling the safe handling of high‑risk infectious agents while preserving experimental fidelity.


Our pulmonary hypertension model, developed using alveolar endothelial and/or epithelial cells, replicates key pathological features such as increased vascular permeability (indicated by reduced TEER) and elevated inflammatory markers. This physiologically relevant platform is suitable for efficacy testing of therapeutic candidates.

Interested in our custom models?
Lung, Gut, Liver, and more — fully human, fully ready.

